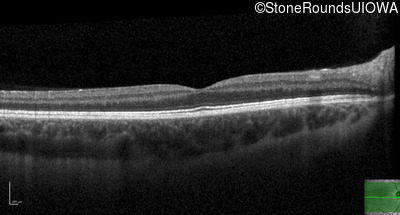
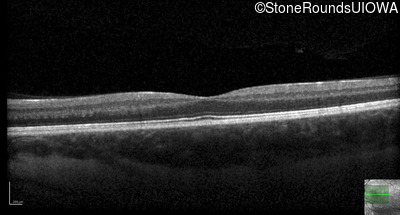

Case
SR6400
Student Mode
Leber Hereditary Optic Neuropathy (IIIC1c)
Male
Male
Hidden
SR6400
Student Mode
Leber Hereditary Optic Neuropathy (IIIC1c)
Male
Male
Highlighted Images
| Age at visit: 22 years | OD | OS |
|---|---|
History
This 22 year old man first noticed blurry vision, more so in the right eye than the left, about 6 months ago.
| Age at visit: 22 years |
| OD | OS | ||
|---|---|---|---|
| OD | OS | ||
|---|---|---|---|
| OD | OS | ||
|---|---|---|---|
| OD | OS | ||
|---|---|---|---|
Diagnosis & molecular findings
| Disease | Gene | Allele 1 variant(s) | Allele 2 variant(s) | Inheritance mode |
|---|---|---|---|---|
| Leber Hereditary Optic Neuropathy | MT-ND4 | 11778 A>G | MT |
Disease:
Gene:
Allele 1:
11778 A>G
Allele 2:
Inheritance:
MT